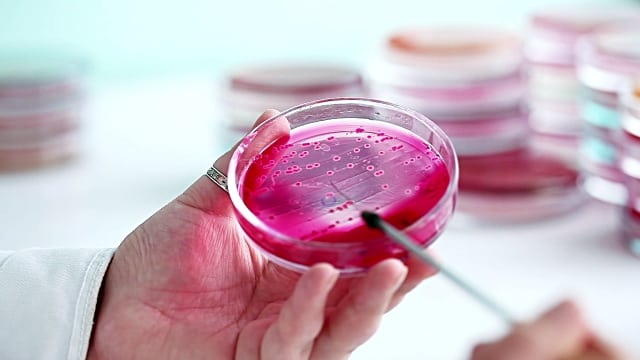

Mai mult timp în aer liber ţine miopia departe
Până în 2050 unul din doi oameni vor fi miopi Noile obiceiuri de viață, ca și multele ore petrecute în fața unor dispozitive electronice și

Până în 2050 unul din doi oameni vor fi miopi Noile obiceiuri de viață, ca și multele ore petrecute în fața unor dispozitive electronice și

Cele mai multe maladii au denumiri care sperie mai mult decât însăşi boala, însă în cazul Leucodistrofiei metacromatice, situaţia este deosebit de serioasă şi cere

Numărătoarea finală a voturilor de la referendumul de joi din Marea Britanie confirmă că majoritatea britanicilor au optat pentru Brexit, respectiv ieşirea ţării lor din

În perioada 27 iunie – 29 iunie 2016 se desfășoară examenul național Evaluarea Națională la clasa a VIII-a. În județul Cluj s-au înscris în vederea

Primăria şi Consiliul Local al Municipiului Câmpia Turzii împreună cu Unitatea Militară 01969 Câmpia Turzii, vă invită să luaţi parte la manifestările care au loc

Până în 2050 unul din doi oameni vor fi miopi Noile obiceiuri de viață, ca și multele ore petrecute în fața unor dispozitive electronice și
Cele mai multe maladii au denumiri care sperie mai mult decât însăşi boala, însă în cazul Leucodistrofiei metacromatice, situaţia este deosebit de serioasă şi cere

Numărătoarea finală a voturilor de la referendumul de joi din Marea Britanie confirmă că majoritatea britanicilor au optat pentru Brexit, respectiv ieşirea ţării lor din

În perioada 27 iunie – 29 iunie 2016 se desfășoară examenul național Evaluarea Națională la clasa a VIII-a. În județul Cluj s-au înscris în vederea

Primăria şi Consiliul Local al Municipiului Câmpia Turzii împreună cu Unitatea Militară 01969 Câmpia Turzii, vă invită să luaţi parte la manifestările care au loc